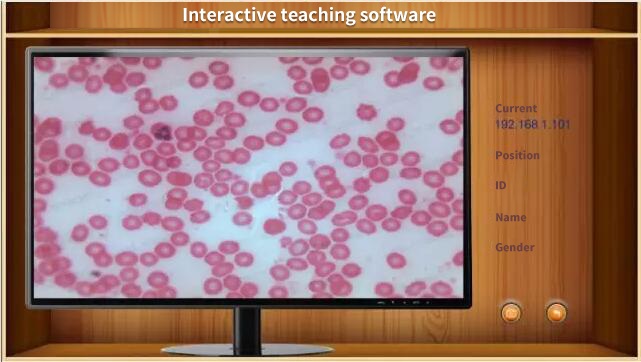
635957202650802926.jpg

Interactive System Case Study
Author : superadmin
Date : 12/04/2015
Views : 3805
Return

The construction of this interactive teaching system was successfully completed by connecting a total of 25 cameras, including 24 cameras on the student end and 1 camera on the teacher end, through wireless routing.

This interactive teaching system uses Magic Eyes series cameras for wireless transmission, saving a lot of construction wiring work in engineering. Assembly is simple and fast, saving unnecessary costs of construction wiring. Simultaneously facilitating rapid communication and interaction between teachers and students. The use of wireless interactive teaching system not only increases the operating space and aesthetics of the laboratory, but also reduces the safety hazards caused by cumbersome wiring during the experimental process for students.

The teacher end can watch real-time dynamic videos of all student ends through interactive teaching software.

Double click on a student interface on the teacher's end to zoom in and view the detailed image of the student interface. The output of each camera is clear, smooth, and distortion free. At the same time, the teacher can remotely control and adjust each student interface through a wireless interactive teaching system, providing one-on-one real-time guidance.

The interactive teaching software for teachers can also support switching between mobile devices, such as Android tablets or smartphones. Teachers can conveniently use handheld mobile devices to watch student videos, greatly improving teaching level and convenience.

Traditional interactive teaching systems are usually connected through tedious on-site wiring, and each device must be equipped with a computer host to achieve interactive teaching applications. The wireless transmission function of our newly developed Magic Eyes series cameras is matched with our newly developed interactive teaching software, achieving modern wireless interactive teaching. Not only does it improve the level of interactive teaching, but compared to traditional interactive teaching systems, it also saves you the cost of wiring and matching computer hosts.
Magic Eyes cameras are the best choice for building modern interactive teaching systems. For more information on Magic Eyes cameras, please refer to